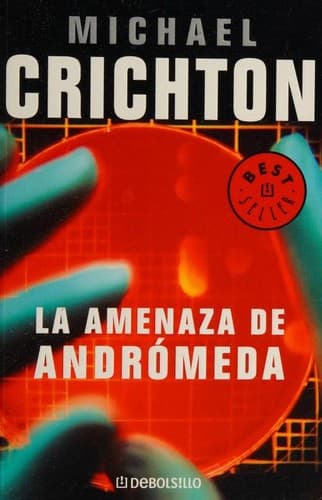
La amenaza de Andrómeda

Orden de Lectura
Andromeda
Comience con La amenaza de Andrómeda y continúe con los 2 libros en el orden de lectura indicado.
Comience Aquí

Comience con La amenaza de Andrómeda
Libro 1 por Michael Crichton
Use el orden de lectura de arriba para avanzar en la serie en la secuencia prevista.
Lista Completa
Orden de lectura de Andromeda
Termina con The Andromeda Evolution
- 1
Libro 1:La amenaza de Andrómeda
Michael Crichton
Use el orden de lectura de arriba para avanzar en la serie en la secuencia prevista.
- 2

Libro 2:The Andromeda Evolution
Michael Crichton • 2019
Fifty years after the first Andromeda incident, a strange anomaly appears deep in the Amazon. A handpicked team investigates while an astronaut tracks events from orbit, facing a new, evolving microorganism and human...
Respuestas Rápidas
FAQ Andromeda
¿Cuál es el mejor orden para leer la serie Andromeda?
El orden de lectura recomendado es el orden numerado que se muestra en esta página, comenzando con La amenaza de Andrómeda.
¿Cuántos libros hay en la serie Andromeda?
Actualmente hay 2 libros listados en la serie Andromeda en GurusReads.
¿Por dónde debo empezar con la serie Andromeda?
Los nuevos lectores deben comenzar con La amenaza de Andrómeda, el primer libro en el orden de lectura.
¿Está completa la serie Andromeda?
Según los años de publicación que tenemos, la serie parece estar probablemente completa y abarca lanzamientos desde 2019.